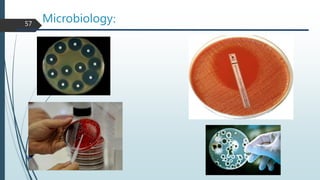
Microbiology:
57

Routine Laboratory Investigations discusses the need for and types of laboratory investigations that can be performed. It covers classifications of tests based on where they are done, their sensitivity and specificity, and frequency of use in dental practice. Commonly used hematological investigations include complete blood count, erythrocyte sedimentation rate, bleeding time, and clotting time. Tests of blood glucose levels are among the most frequently used serum chemistry investigations. The document emphasizes correctly interpreting results in the context of a patient's history and clinical findings.

![Applications
63
Medical diagnostic to detect presence of antibodies in patient
HIV Test
But: high material costs
Drug tests
West Nile Virus
Slides by Mathias Bader and Simon Loew
ELISA test identifies P. gingivalis and C. rectus . By test. P. gingivalis,
as identified by ELISA, had the highest degree of sensitivity and
specificity (0.90 and 0.82 respectively) to clinical indicators of adult
periodontitis. [J Periodontol 1994;65:576–582].](https://image.slidesharecdn.com/routinelaboratoryinvestigations-221021052210-f1a09e0e/85/Routine-Laboratory-Investigations-pdf-63-320.jpg)











